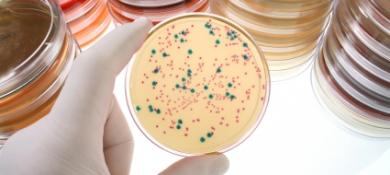
Stopping Swine Fever

La Crise pousse les étudiants anglais à changer leur comportement face aux études.
4Shbab and Music Videos in Egypt
[Article] Avec 4Shbab, l'Egypte lance la première station de musique et de vidéo respectant les principes de l'Islam.
Si vous ne connaissez pas un mot, surlignez-le avec votre souris et cliquez sur “Translate” pour le traduire dans la langue de votre choix.
Profitez de la lecture automatique avec accent avec un abonnement
The world's first Islamic music television station has opened in Cairo, Egypt. The station, called 4Shbab (meaning 'for the youth') broadcasts music videos, interviews artists and hosts game shows with audience participation, all meant to gently impart mainstream Islamic law ...
Accédez à l'intégralité de l'article, choisissez un abonnement